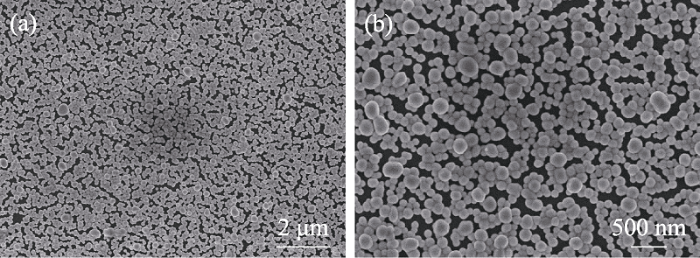

作为一类有代表性的金属硫属化合物, 硒化银(Ag2Se)以其独特的物理特性而受到广泛关注。室温下, Ag2Se晶格结构为正交相, 晶格内的两个Ag原子处于不同的晶格位点, 其中一个是四面体配位, 另一个的配位面更倾向于三角形。Ag2Se是一种能隙较窄(Eg≈0.15 eV)的n型半导体材料[1]。而410 K以上, Ag2Se的晶型转变为立方相, 此时Se的晶格排列在bcc晶格中, 构成稳定的骨架, 同时Se八面体和四面体之间形成[100]通道, Ag离子则在通道中自由移动, Ag2Se即由半导体转变为超离子导体[2]。近年来, Ag2Se被广泛用于荧光量子点材料[3⇓-5]、量子点太阳能电池[6]、热电材料[7⇓⇓-10]和巨磁电阻材料[11-12]。
微型器件的迅速发展使低尺度薄膜材料的制备受到了特别的关注。目前, 多采用真空抽滤法[13⇓-15]、热蒸发法[16-17]与脉冲激光沉积法[18]制备Ag2Se薄膜。例如, Ding等[19]通过化学合成法获得了具有微纳结构的Ag2Se, 通过真空抽滤法在尼龙衬底上制备得到了Ag2Se薄膜; Zhou等[20]则将Ag与Se的块体靶材作为原料, 采用脉冲激光沉积法在玻璃衬底上制备了Ag2Se薄膜材料。然而, 上述工艺往往难以精准控制薄膜尺寸, 更无法对薄膜进行图案化设计, 这不利于薄膜材料在微型器件中的构筑与布局。喷墨打印是一种低成本、高效、高精度的数字化印刷工艺, 打印时无需掩模或模板辅助, 通过编辑位元图形即可将各种墨水喷印制备为薄膜[21-22], 且对多种承印基板均具有较好的兼容性,是特别适合一体化制备微电子器件的工艺技术[23⇓-25]。然而, 目前尚无通过喷墨打印技术制备Ag2Se薄膜的报道, 这可能是墨水配制与工艺优化方面还存在难以解决的问题。
本工作采用溶剂热法合成Ag2Se纳米粉体并研究了其在不同分散剂中的稳定性, 从而筛选得到适用于喷墨打印工艺的墨水。在此基础上, 通过调节打印参数, 实现了墨滴的顺利喷射与形态优化, 利用喷墨打印技术制备了Ag2Se薄膜, 并对其电学性能进行了研究。
1 实验方法
1.1 实验试剂
硝酸银(AR, 国药集团化学试剂有限公司); 二氧化硒(99.9%, 阿拉丁生化科技股份有限公司); 油酸(AR, 上海麦克林生化科技有限公司); N,N-二甲基甲酰胺(AR, 国药集团化学试剂有限公司); 聚乙烯吡咯烷酮(K30, 国药集团化学试剂有限公司); 无水乙醇(CP, 国药集团化学试剂有限公司); 丙酮(CP, 国药集团化学试剂有限公司)。
1.2 实验仪器
喷墨打印机(DMP-2850, 美国FUJIFILM公司); 管式炉(OTF-1200X, 合肥科晶材料技术有限公司); X射线衍射仪(DX-2700B, HAOYUAN); 场发射扫描电子显微镜(TESCAN MAIA 3, Czech republic); 四探针测试仪(Loresta-GX MCP-T700, 日本三菱化学)。
1.3 Ag2Se纳米颗粒与墨水的制备
采用溶剂热法合成Ag2Se纳米颗粒[26]。量取40 mL N,N-二甲基甲酰胺和20 mL油酸置于烧杯中, 依次加入1 g聚乙烯吡咯烷酮、0.16 g硝酸银和0.052 g二氧化硒, 搅拌均匀后将溶液转移至水热釜中, 在120 ℃下反应12 h。反应结束后将产物转移至离心管, 以10000 r/min的转速离心5 min, 除去上清液, 并在相同条件下使用乙醇和丙酮对产物离心洗涤。洗涤后的产物在60 ℃真空烘箱中干燥6 h。
采用超声分散法制备Ag2Se墨水, 将50 mg Ag2Se粉末分散在20 mL去离子水(DI-water)、乙醇(Ethanol)或乙二醇(EG)等不同分散剂中, 在超声分散仪中超声1 h, 超声结束后静置待用。
1.4 Ag2Se墨水的喷墨打印与热处理
抽取约1.5 mL Ag2Se墨水, 使用注射器将墨水缓慢注入喷墨打印机专用的墨盒中。在喷墨打印机的计算机控制软件中设置打印图案, 将墨水打印至聚酰亚胺衬底上。打印液滴间距为20 μm, 打印层数为40层。打印结束后, 将样品放入管式炉中, 在Ar/H2混合气气氛中进行热处理, 升温速率为10 ℃/min, 并在450 ℃下保持10 min。
2 结果与讨论
2.1 Ag2Se粉体物相和形貌表征
鉴于喷墨打印机的喷嘴直径较小(约21 μm), 墨水中含有的材料粒径应尽可能地减小至纳米级, 以防止在打印过程中堵塞喷嘴。图1展示了通过溶剂热法合成的Ag2Se粉体的X射线衍射(XRD)图谱, 图谱中的大多数衍射峰与Ag2Se的标准卡片(PDF#24-1041)相对应, 而2θ=38°、45°和65°处的衍射峰则对应于Ag的标准卡片(PDF#04-0783), 说明产物中包含Ag单质, 这可能是部分二氧化硒未被还原所致。
图1
图2为溶剂热法合成Ag2Se粉体的SEM照片, 从图中可以看出, 合成产物为粒径100~200 nm的圆形纳米颗粒, 且呈单分散状态, 几乎不存在团聚现象。这是由于合成时加入的表面活性剂(聚乙烯吡咯烷酮)与配体(油酸)降低了Ag2Se纳米颗粒的表面能, 抑制了晶粒长大和团聚。因此, 采用溶剂热法合成的Ag2Se粉体可以满足喷墨打印用墨水的要求。
图2
图2
Ag2Se粉体的SEM照片
Fig. 2
SEM images of Ag2Se powder
(a) Low-resolution; (b) High-resolution
2.2 分散剂对Ag2Se墨水稳定性的影响
图3为溶剂热法合成的Ag2Se粉体分散在去离子水、乙二醇和乙醇中配制成的墨水。这3种墨水经过超声分散后都具有较好的分散性(图3(a)), 而经过12 h后, Ag2Se-水墨水出现了较为明显的沉降, Ag2Se-乙二醇墨水只出现了轻微的沉降, 而Ag2Se-乙醇墨水依然保持了原有的分散性, 表现出良好的稳定性。造成这一差异的原因在于: Ag2Se纳米颗粒表面的表面活性剂(聚乙烯吡咯烷酮)和表面配体(油酸)与溶剂之间存在相溶性差异, 其中乙醇对这两类表面改性物质均表现出良好的溶解度, 使得纳米颗粒能够在分散剂中稳定存在, 依靠彼此间的空间位阻进一步维持体系的稳定性。此外, 纳米颗粒尺寸较小且不团聚, 避免了因重力作用产生的沉降。因此, 本研究选择Ag2Se-乙醇墨水进行后续的喷墨打印。
图3
图3
溶剂热法合成的Ag2Se粉体在不同溶剂中的分散性和稳定性
Fig. 3
Dispersion and stability of Ag2Se powders synthesized by solvothermal method in different solvents
(a) Optical images of Ag2Se ink after ultrasonic dispersion; (b) 12-h still-standing
2.3 墨滴形态优化
为了提高喷墨打印质量, 需要对液滴形态进行优化。避免卫星滴是墨滴形态优化的重要目标之一, 卫星滴是指墨滴从喷嘴处喷射出后从主液滴分裂出的其他小液滴, 若喷射过程中出现卫星滴, 液滴之间的距离过近, 主液滴尚未在衬底上完全铺展而卫星滴就已与衬底碰撞, 会严重影响薄膜的均匀度与图案精度。喷射波形和喷嘴电压是影响墨水是否能顺利喷射和液滴形态的关键参数。基于打印机出厂预设的DI-water波形, 可以通过调节喷嘴电压对墨滴的飞行形态进行优化。图4为设置不同喷嘴电压时液滴形态的变化情况。如图4(a, b)所示, 当喷嘴电压为18 V时, 墨水喷射后前端形成圆球状液滴, 后端的液柱较短, 在飞行过程中, 由于表面张力的作用, 后端液柱与前端液滴合并为单个液滴下落。如果将喷嘴电压增加至21 V(图4(b, e)), 液滴上方的液柱变长, 形成明显的拖尾, 拖尾在后续过程中则与主液滴分离形成两个卫星滴。如图 4(c, f)所示, 若喷嘴电压进一步增大至26 V, 液柱形成的拖尾更长, 在飞行过程中也不可避免地形成卫星滴。喷嘴电压越大, 喷嘴的压电模块的形变程度也随之变大, 使得墨水受到更强的挤压, 从而导致喷射出喷嘴的液柱变长[27]。另一方面, 在同一个喷射周期中, 压电模块发生形变后会逐渐恢复原状, 如果其初始的形变程度较大, 则在恢复形状时会产生更大的反向吸引力, 这就使得液柱形成更多的卫星滴而非汇聚进主液滴中[28]。对于喷墨打印, 应尽量避免墨水在喷射过程产生的卫星滴, 因此18 V的喷嘴电压较为合适。
图4
图4
设置不同喷嘴电压时的液滴形态
Fig. 4
Shape of droplets with different cartridge voltage setting
(a, d) 18 V; (b, e) 21 V; (c, f) 26 V
2.4 喷墨打印Ag2Se薄膜的物相、结构与电学性能的影响
墨水固含量是影响打印薄膜结构与性能的重要参数。将50 mg Ag2Se纳米粉体分散在40、20或10 mL乙醇中, 配制得到固含量分别为1.25、2.5和5 mg·mL-1 Ag2Se-乙醇墨水。图5为不同固含量墨水打印得到的Ag2Se薄膜的XRD谱图, 可以看出, 固含量为1.25 mg·mL-1墨水打印得到薄膜的衍射峰强度过低, 说明薄膜的结晶度很差, 这是由于墨水固含量太低, 沉积在衬底上的Ag2Se颗粒过少。固含量为2.5和5 mg·mL-1墨水打印得到的薄膜在2θ=23°和47°处出现两个强峰分别对应于β-Ag2Se的(002)和(004)晶面(PDF#24-1041), 而其它衍射峰几乎不可见。其中5 mg·mL-1墨水打印得到薄膜的衍射峰强度明显超过2.5 mg·mL-1墨水对应的样品, 说明随着墨水固含量增加, 薄膜在退火后的结晶度也更高。与Ag2Se粉体的XRD谱图对比可发现,薄膜退火后沿(002)和(004)晶面的取向程度大大增加, 这一现象与文献[16]报道结果相一致。在450 ℃保温过程中, Ag2Se呈高温立方相晶型; 样品随炉体缓慢降温过程中, Ag2Se的晶型从立方相向低温正交相转变, 由于正交相中(00l)面的表面能低, 且两种晶型(00l)面的表面能差距较大, 因此Ag2Se内部原子重排时表现出强烈的沿(00l)面的选择性取向, 最终导致Ag2Se薄膜的XRD谱图中只出现(002)和(004)晶面对应的高强度衍射峰[29]。同时, 薄膜的XRD谱图中还出现了与Ag单质(PDF#04-0783)相对应的衍射峰, 这符合Ag2Se粉体中含有Ag第二相的现象。
图5
图5
不同固含量墨水打印制备的Ag2Se薄膜的XRD谱图
Fig. 5
XRD patterns of Ag2Se films corresponding to different ink concentrations
图6为使用不同固含量的墨水打印得到的Ag2Se薄膜的SEM照片。当墨水固含量为1.25 mg·mL-1时, Ag2Se薄膜内部的晶粒多以孤立状态存在, 只有少量晶粒经过退火过程得以烧结而连接, 薄膜内部孔隙多, 致密度差, 如图6(a~b)所示。当墨水固含量增大至2.5 mg·mL-1时, 晶粒彼此之间经过烧结相互连接, 但连接依然不充分, 薄膜的致密性较差(图6(c~d))。而当墨水固含量为5 mg·mL-1时, 打印得到的薄膜的致密度得到明显的提升(图6(e)), 这是因为随着墨水固含量提升, 每滴墨水中含有更多的Ag2Se颗粒, 这些颗粒沉积在衬底上之后堆积更密集, 颗粒间接触得更多, 使得薄膜经历退火后致密化程度大大提高, 如图6(f)所示。这说明使用5 mg·mL-1的Ag2Se墨水打印并退火得到的薄膜具有较好的致密度。
图6
图6
不同固含量墨水打印制备的Ag2Se薄膜的SEM照片
Fig. 6
SEM images of Ag2Se films printed with different ink concentrations
(a-b) 1.25 mg·mL-1; (c-d) 2.5 mg·mL-1; (e-f) 5 mg·mL-1
进一步测试不同固含量墨水制备的Ag2Se薄膜的电导率。当墨水固含量为1.25 mg·mL-1时, 制备的薄膜的电阻值过大, 几乎不导电。固含量为2.5 mg·mL-1的墨水制备的Ag2Se薄膜的电导率仅为1.7 S·cm-1。上述两样品的电性能低应归咎于其内部较低的结晶度和致密度。当墨水固含量升高至5 mg·mL-1后, Ag2Se薄膜的导电性能得到显著提升, 其室温电导率可达399 S·cm-1, 表现出较好的导电性能。
借助喷墨打印机程序设置中的“Pattern editor”功能, 对图案的打印层数进行设置, 以便实现图案的自动化重复印制。重点研究打印层数对Ag2Se薄膜物相、结构和电性能的影响。
图7为打印10、20、30和40层的Ag2Se薄膜退火后的XRD谱图, 各样品在2θ=23°和47°处的两个强峰分别对应于β-Ag2Se的(002)和(004)晶面(PDF#24-1041), 而其它晶面的衍射峰几乎不可见。随着打印层数的增加, Ag2Se薄膜的衍射峰强度也随之上升, 这说明增加打印层数有利于提高薄膜结晶度。位于2θ=38°和44°处的衍射峰则对应于Ag的(111)和(200)晶面(PDF#04-0783), 表明退火后薄膜内部存在第二相Ag。
图7
图7
不同打印层数的Ag2Se薄膜的XRD谱图
Fig. 7
XRD patterns of Ag2Se films with different printing layers
图8为打印10、20、30和40层的Ag2Se薄膜的SEM照片。如图8(a~b)所示, 当打印层数为10层时, Ag2Se薄膜内部含有大量的微米级的孔隙,而当打印层数增加到20层时(图8(c~d)), 孔隙的尺寸和数量明显减少。打印层数增加后, Ag2Se颗粒的沉积量增加, 并倾向于在衬底表面铺展, 因此Ag2Se薄膜的连续性得到较大的提升。值得注意的是, 当打印层数增加至30层后, Ag2Se薄膜内部的孔隙并未进一步减少, 而Ag2Se颗粒出现了上下堆叠的现象, 如图8(e~f)所示。这表明在打印过程中, 后续沉积在衬底上的Ag2Se颗粒并未在衬底上铺展, 而是堆积在覆盖衬底表面的Ag2Se颗粒之上; 在后续退火过程中, 上层的Ag2Se颗粒也并不倾向于填充下层Ag2Se颗粒间的空隙, 而是和水平方向上的颗粒烧结相连。如图8(g~h)所示, 当打印层数继续增加至40层时, Ag2Se薄膜的孔隙继续减少, 致密度有所提高。这可能是由于不同高度的Ag2Se颗粒各自与水平方向上的颗粒烧结致密化, 而上下层结构相互交织, 从而减少了孔隙。
图8
图8
不同打印层数的Ag2Se薄膜的SEM照片
Fig. 8
SEM images of Ag2Se films with different printing layers
(a-b) 10 layers; (c-d) 20 layers; (e-f) 30 layers; (g-h) 40 layers
图9为Ag2Se薄膜的导电性能随打印层数的变化情况。随着打印层数的增加, Ag2Se薄膜的电导率不断提高, 电导率114.2 S·cm-1(10层)提高至399 S·cm-1(40层)。打印层数增加使得沉积在衬底上的Ag2Se颗粒增多, 堆积密集程度增加, 从而减少了薄膜退火后内部的孔隙, 增加了导电通路, 使得电导率得到显著提高。值得注意的是, 喷墨打印Ag2Se薄膜的电导率仍低于一些使用真空抽滤和气相沉积法制备的Ag2Se薄膜[14,16,20], 这是因为溶剂热法合成的Ag2Se纳米颗粒表面存在不导电的聚乙烯吡咯烷酮, 而其无法在退火的Ar/H2气氛中被有效除去, 从而限制了薄膜导电性能, 也不利于Ag2Se纳米颗粒间的烧结致密化, 这个不足希望在今后的工作中得到改善。
图9
图9
Ag2Se薄膜的电性能与打印层数之间的关系
Fig. 9
Electrical conductivity of Ag2Se films as a function of printing layers
图10为利用喷墨打印技术制备的“DHU”字样的图案, 展示了这一技术在印制复杂图案和精度控制上的独特优势。
图10
3 结论
本研究实现了Ag2Se墨水的制备与喷墨打印。采用溶剂热法成功合成了粒径为100~200 nm的Ag2Se纳米颗粒, 得益于其表面的表面活性剂与配体, Ag2Se纳米颗粒在乙醇分散剂中表现出良好的分散性和稳定性, 从而得到了适用于喷墨打印的Ag2Se墨水。通过调节喷射参数, 成功实现了墨滴的顺利喷射和形态优化, 避免了卫星滴的产生, 提升了打印质量。进一步研究了打印Ag2Se薄膜的结构、电学性能与墨水固含量、打印层数之间的关系, 当墨水固含量为5 mg·mL-1, 打印层数为40层时, Ag2Se薄膜具有良好的结晶度与致密度, 其室温电导率可达399 S·cm-1, 表现出较好的电学性能, 有望在柔性热电材料与器件、荧光量子点等领域获得广泛应用。
参考文献
Novel synthesis recipes boosting thermoelectric study of A2Q (A = Cu, Ag; Q = S, Se, Te).
Superionic phase transition in silver chalcogenide nanocrystals realizing optimized thermoelectric performance
Thermoelectric has long been recognized as a potentially transformative energy conversion technology due to its ability to convert heat directly into electricity. However, how to optimize the three interdependent thermoelectric parameters (i.e., electrical conductivity σ, Seebeck coefficient S, and thermal conductivity κ) for improving thermoelectric properties is still challenging. Here, we put forward for the first time the semiconductor-superionic conductor phase transition as a new and effective way to selectively optimize the thermoelectric power factor based on the modulation of the electric transport property across the phase transition. Ultra low value of thermal conductivity was successfully retained over the whole investigated temperature range through the reduction of grain size. As a result, taking monodisperse Ag(2)Se nanocrystals for an example, the maximized ZT value can be achieved around the temperature of phase transition. Furthermore, along with the effective scattering of short-wavelength phonons by atomic defects created by alloying, the alloyed ternary silver chalcogenide compounds, monodisperse Ag(4)SeS nanocrystals, show better ZT value around phase transition temperature, which is cooperatively contributed by superionic phase transition and alloying at nanoscale.© 2012 American Chemical Society
Integration of fluorescence/ photoacoustic imaging and targeted chemo/photothermal therapy with Ag2Se@BSA-RGD nanodots
Ultrasmall near-infrared Ag2Se quantum dots with tunable fluorescence for in vivo imaging
Facile synthesis of highly photoluminescent Ag2Se quantum dots as a new fluorescent probe in the second near-infrared window for in vivo imaging
Photovoltaic performance of Ag2Se quantum dots co-sensitized solid-state dye sensitized solar cells
Structural stability enables high thermoelectric performance in room temperature Ag2Se
Effect of nonstoichiometry on the thermoelectric properties of a Ag2Se alloy prepared by a mechanical alloying process
Thermoelectric transport of Se-rich Ag2Se in normal phases and phase transitions
Technologies and applications of thermoelectric devices: current status, challenges and prospects
Magnetoresistance in microwave synthesized Ag2+θSe (0.0≤θ≤0.2)
Magnetoresistance effect of silver selenide thin films fabricated by magnetron sputtering
Thermoelectric flexible silver selenide films: compositional and length optimization
Ultrahigh performance of n-type Ag2Se films for flexible thermoelectric power generators
Ultrahigh performance polyvinylpyrrolidone/Ag2Se composite thermoelectric film for flexible energy harvesting
High performance wearable thermoelectric generators using Ag2Se films with large carrier mobility
Enhanced thermopower in (013)-oriented silver selenide films produced by thermal annealing
Thermoelectric power of annealed β-Ag2Se alloy thin films: Temperature and size effects-possibility of a new (β2) phase at low temperatures
High performance n-type Ag2Se film on Nylon membrane for flexible thermoelectric power generator
Non-epitaxial pulsed laser deposition of Ag2Se thermoelectric thin films for near-room temperature applications
Study of preparation of BZN ceramic ink.
Graphene nanosheets prepared by arc discharge method and their application in conductive inkjet
Inkjet printing wearable electronic devices
A review on inkjet printing of nanoparticle inks for flexible electronics
Inkjet-printing and performance investigation of self-powered flexible graphene oxide humidity sensors
Tetragonal-orthorhombic-cubic phase transitions in Ag2Se nanocrystals
Analysis and research of the ink-jet printing quality
Parameter analysis of droplet ejection of piezoelectric ink-jet printing